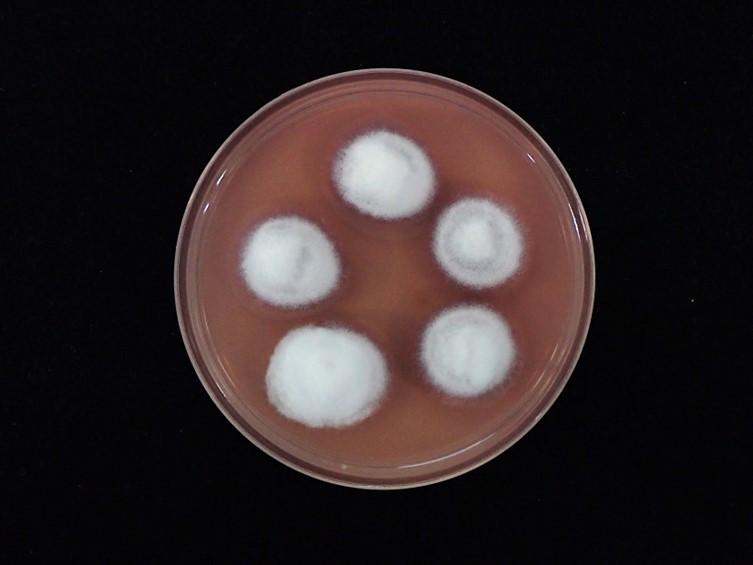

Holotype:
PAPUA NEW GUINEA, Keravat, 23 Mar. 1980, ex-type living culture CBS 610.80.
Habitat:
Underside of dicotyledonous leaves.
Host:
Spiders (Araneae; Theridiidae).
Description:
Spider hosts covered by light yellow to pale yellow mycelium. Sexual morph:  Stromata stipitate, solitary or multiple. Stipes cylindrical, arising from the dorsal region of the host, white to pale yellow, 3-5 mm long, 0.5-1 mm broad. Fertile heads produce at the terminal of stipes, disc-shaped, upper surface slightly convex, 1-3 × 1-2 mm.
Stromata stipitate, solitary or multiple. Stipes cylindrical, arising from the dorsal region of the host, white to pale yellow, 3-5 mm long, 0.5-1 mm broad. Fertile heads produce at the terminal of stipes, disc-shaped, upper surface slightly convex, 1-3 × 1-2 mm.  Perithecia completely immersed, narrowly ovoid, 500-750 × 200-300 μm, ostioles strong orange yellow.
Perithecia completely immersed, narrowly ovoid, 500-750 × 200-300 μm, ostioles strong orange yellow.  Asci cylindrical, 8-spored, 350-450 μm long, 5-7 μm broad, with cap 3-5 μm thick.
Asci cylindrical, 8-spored, 350-450 μm long, 5-7 μm broad, with cap 3-5 μm thick.  Ascospores hyaline, filiform, whole ascospores, 400-460 × 1-1.5 μm. Asexual morph: Synnemata multiple, cylindrical, occasionally acuminate apex, white, up to 8 mm long, 50-200 μm broad. Conidiogenous cells phialidic, scattered along with the synnemata.
Ascospores hyaline, filiform, whole ascospores, 400-460 × 1-1.5 μm. Asexual morph: Synnemata multiple, cylindrical, occasionally acuminate apex, white, up to 8 mm long, 50-200 μm broad. Conidiogenous cells phialidic, scattered along with the synnemata.  Phialides solitary, globose to subglobose, arising from the mycelium, 4-6 × 4-6 μm, with distinct necks, 0.5-1.5 × 0.5-1 μm.
Phialides solitary, globose to subglobose, arising from the mycelium, 4-6 × 4-6 μm, with distinct necks, 0.5-1.5 × 0.5-1 μm.  Conidia hyaline, fusoid or fusiform-elliptical, 2-10 × 1-2.5 μm.
Conidia hyaline, fusoid or fusiform-elliptical, 2-10 × 1-2.5 μm.
Culture characteristics:
Colonies on PDA attaining a diam of 7–10 mm in 21 d, cottony with high mycelium density, white, moderate purplish-red to dark purplish-pink pigment diffusing in the medium, reverse moderate red. Sporulation observed after 30 d with absence of synnemata. Phialides arising from aerial hyphae, solitary, mostly globose to subglobose, occasionally cylindrical, 4–5 × 2–5 μm, distinct necks, 0.5–2 × 0.5–1 μm. Conidia hyaline, fusoid, fusiform-elliptical, cylindrical, 2–11 × 1–3 μm.
Colonies on PDA attaining a diam of 7–10 mm in 21 d, cottony with high mycelium density, white, moderate purplish-red to dark purplish-pink pigment diffusing in the medium, reverse moderate red. Sporulation observed after 30 d with absence of synnemata. Phialides arising from aerial hyphae, solitary, mostly globose to subglobose, occasionally cylindrical, 4–5 × 2–5 μm, distinct necks, 0.5–2 × 0.5–1 μm. Conidia hyaline, fusoid, fusiform-elliptical, cylindrical, 2–11 × 1–3 μm.
Other Available strains
TBRC-BCC 47869 , TBRC-BCC 47876 , TBRC-BCC 47877 , TBRC-BCC 47878 , TBRC-BCC 47880 , TBRC-BCC 47881 , TBRC-BCC 47894 , TBRC-BCC 47895Reference:
Mongkolsamrit S, Noisripoom W, Tasanathai K, et al. (2022). Comprehensive treatise of Hevansia and three new genera Jenniferia, Parahevansia and Polystromomyces on spiders in Cordycipitaceae from Thailand. MycoKeys 91: 113–149.
DOI: https://doi.org/10.3897/mycokeys.91.83091Species |
Strain |
Compound |
Pubchem CID |
Biological activity |
Reference |
|---|---|---|---|---|---|
| Hevansia novoguineensis | TBRC-BCC 47869 | Akanthopyrone A (1) | 159931 | Antimicrobial acitvity against S. aureus; Antimicrobial acitvity against E. coli | Kuephadungphan et al. 2017 |
| Hevansia novoguineensis | TBRC-BCC 47876 | Akanthopyrone B (2) | 159931 | Antimicrobial acitvity against S. aureus; Antimicrobial acitvity against E. coli | Kuephadungphan et al. 2017 |
| Hevansia novoguineensis | TBRC-BCC 47877 | Akanthopyrone C (3) | 159931 | Antimicrobial acitvity against S. aureus; Antimicrobial acitvity against E. coli | Kuephadungphan et al. 2017 |
| Hevansia novoguineensis | TBRC-BCC 47878 | Akanthopyrone D (4) | 159931 | Antimicrobial acitvity against S. aureus; Antimicrobial acitvity against E. coli | Kuephadungphan et al. 2017 |
| Hevansia novoguineensis | TBRC-BCC 47880 | Akanthol (5) | 159931 | Antimicrobial acitvity against S. aureus; Antimicrobial acitvity against E. coli | Kuephadungphan et al. 2017 |
| Hevansia novoguineensis | TBRC-BCC 47881 | Akanthozine (6) | 159931 | Antimicrobial acitvity against S. aureus; Antimicrobial acitvity against E. coli | Kuephadungphan et al. 2017 |
| Hevansia novoguineensis | TBRC-BCC 47894 | 2-(N-hydroxyisobutyramide)-3-methylbutanamide (7) | 159931 | Antimicrobial acitvity against S. aureus; Antimicrobial acitvity against E. coli | Kuephadungphan et al. 2017 |
| Hevansia novoguineensis | TBRC-BCC 47895 | N-hydroxy-2-(N-hydroxyisobutyramido)-3-methylbutanamide (8) | 159931 | Antimicrobial acitvity against S. aureus; Antimicrobial acitvity against E. coli | Kuephadungphan et al. 2017 |
| Hevansia novoguineensis | TBRC-BCC 47895 | 4-hydroxy-3,5-diisopropyl-1,2,4-oxadiazinan-6-one (9) | 159931 | Antimicrobial acitvity against S. aureus; Antimicrobial acitvity against E. coli | Kuephadungphan et al. 2017 |
|
Strain |
ITS | LSU | RPB2 | TEF1 |
|---|---|---|---|---|
| BCC 2190 | MF416531 | - | MF416474 | |
| BCC 42675 | MZ684089 | MZ684004 | MZ707835 | MZ707814 |
| BCC 49323 | MZ684090 | MZ684005 | MZ707836 | MZ707813 |
| CBS 610.80 | MH532831 | MH394646 | MH521844 | MH521885 |